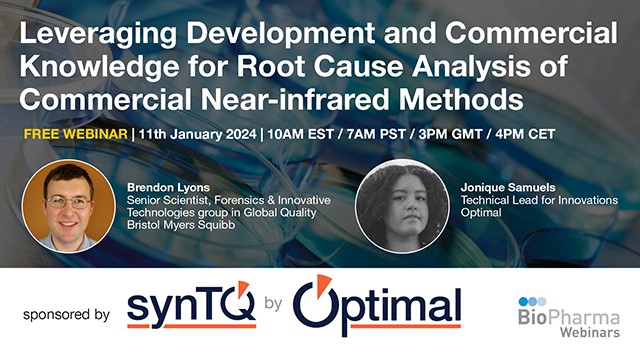

#processanalyticaltechnology 搜索结果
Maximize yield, quality, and sustainability with our Real-Time Reaction Analysis Guide! #SyntheticChemistry #ProcessAnalyticalTechnology #RealTimeAnalysis #Sustainability #Innovation #METTLERTOLEDO #AutoChem okt.to/QeCh0l
This application note explores how integrating Bruker’s Fourier 80 benchtop NMR with a PAT software platform enables online and in-line reaction monitoring. Read more: goto.bruker.com/469kwoV #NMR #Pharma #ProcessAnalyticalTechnology #BenchtopNMR
The global #processanalyticaltechnology market size accounted for USD 2.94 billion in 2022 and is expected to touch around USD 8.21 billion by 2032, growing at a CAGR of 10.82% from 2023 to 2032. #precedenceresearch Read More: bit.ly/3MVtkXM

📌#datafusion #processanalyticaltechnology #chemometrics #processcontrol New Publication “Challenges and Opportunities of Implementing Data Fusion in Process Analytical Technology—A Review” By: Brigitta Nagy, et al. 👉 mdpi.com/1420-3049/27/1… #mdpimolecules #NewPublication

Process Analytical Technology for High Shear Wet Granulation microbiozindia.com/process-analyt… @micromeritics #processanalyticaltechnology #phaarma

毎年ご好評のRXEフォーラムまであと1ヶ月となりました。 年々参加人数も増えているようで、また、ご出席の方同志の交流の場としてもご活用いただけております🤝 ご興味のある方は、ぜひ一度ご参加を☺️ #メトラー・トレド #ProcessAnalyticalTechnology #PAT #バイオプロセス
日本RXEフォーラム ■2024年8月22日開催決定!■ (大田区産業プラザ コンベンションホール) 化学・製薬メーカーおよびアカデミックのユーザー様より、実践的な活用事例をご講演いただきます! お申込み:x.gd/31afv…

New Job!! Specialising in #ProcessAnalyticalTechnology ensuring their advanced products redefine industry standards. They are now seeking a #DataScience professional to help bring their #product to life and have a global impact. Click below tinyurl.com/ysfznxlo

Cloud-based computing: driving next-generation drug development How can #processanalyticaltechnology be used when improving #pharmamanufacturing? ✏️Jonique Samuels, @OptimalLtd_Tech by #SciY Read here: bit.ly/3OJNbZs #AIandML #pharmatech #thecloud

At #BIO2025, #ReciBioPharm unveiled its real-time #ProcessAnalyticalTechnology (PAT) platform for #biomanufacturing. The mobile, modular system supports both process development and large-scale commercial #manufacturing. pharmamanufacturing.com/industry-news/… #Recipharm #biologics #CDMO #CDMOs
At #BIO2025, #ReciBioPharm unveiled its real-time #ProcessAnalyticalTechnology (PAT) platform for #biomanufacturing. The mobile, modular system supports both process development and large-scale commercial #manufacturing. pharmamanufacturing.com/industry-news/… #Recipharm #biologics #CDMO #CDMOs
To read more about Process Analytical Technology (PAT) and find out how to implement it, download a free copy of ‘QbD & PAT for dummies’ from SciY’s member company Optimal Industrial Technologies: goto.bruker.com/3YnJ7lH @OptimalLtd_Tech #ProcessAnalyticalTechnology
Watch our on-demand webinar with Biogen about #ProcessAnalyticalTechnology (PAT) in biopharmaceutical manufacturing. Examine various PAT techniques implemented for real-time monitoring and process control. Watch here: bit.ly/3S89KbL
Hoeveel veiligheid heeft uw proces nodig? Onze nieuwe generatie 80 GHz radarsensoren bieden meer dan genoeg eh.digital/3W2ifph #EndressHauser #ProcessControl #ProcessAnalyticalTechnology

Curious about who we are and what we do at Optimal? Check out this video to see how we help businesses grow and improve processes! 🎥 youtube.com/watch?v=5tdVcu… #SmartManufacturing #ProcessAnalyticalTechnology
youtube.com
YouTube
An Introduction to the Optimal Group
Learn how Optimal is advancing continuous processing with cutting-edge PAT solutions. Boost efficiency, reduce waste, and improve quality. optimal-ltd.co.uk/experience/ #SmartManufacturing #ProcessAnalyticalTechnology
Want to learn about Process Analytical Technology? Check out this great webinar on advances in bioprocessing: biopharmawebinars.com/webinars/proce… #ProcessAnalyticalTechnology #Bioprocessing
Explore how PAT is transforming bioprocessing and digital manufacturing with Martin Gadsby in this on-demand webinar. Watch now: biopharmawebinars.com/webinars/proce… #IndustrialAutomation #ProcessAnalyticalTechnology #Biomanufacturing
Check out this BioPharma_Asia webinar on applying PAT and intelligent control for next-gen manufacturing. Learn about digital evolution and seamless PAT integration. biopharmawebinars.com/webinars/inter… #ProcessAnalyticalTechnology #SmartManufacturing
biopharmawebinars.com
Interface Machine Learning Process Analytical Technology and Process Science For Next Level Process...
The digital evolution as a compelling destination – beyond data-centric knowledge management, opportunities and prerequisites Examples and applications for modeling, machine learning and PAT Seamless...
Unlock the potential of synTQ by Optimal Industrial Technologies! Enhance real-time quality control and operational efficiency with our leading PAT knowledge management platform. Learn more: optimal-ltd.co.uk/syntq-by-optim… #ProcessAnalyticalTechnology #SmartManufacturing
optimal-ltd.co.uk
synTQ by Optimal Industrial Technologies - Optimal Industrial Automation
Explore synTQ, the award-winning Process Analytical Technology (PAT) knowledge management platform. Unlock the power of smart manufacturing with real-time data recording, statistical process control,...
Discover the transformative role of PAT in biopharmaceutical manufacturing. Learn about the challenges and benefits of integrating PAT tools in our latest webinar. Watch now: biopharmawebinars.com/webinars/next-… #ProcessAnalyticalTechnology
biopharmawebinars.com
Next Generation Manufacturing at Biogen – PAT as an Enabler for Enhanced Process
Biogen is among the first biopharmaceutical companies to employ PAT in an active role in the manufacturing of biologicals. The implementation of in-process Raman for glucose control, biocapacitance...
At #BIO2025, #ReciBioPharm unveiled its real-time #ProcessAnalyticalTechnology (PAT) platform for #biomanufacturing. The mobile, modular system supports both process development and large-scale commercial #manufacturing. pharmamanufacturing.com/industry-news/… #Recipharm #biologics #CDMO #CDMOs
At #BIO2025, #ReciBioPharm unveiled its real-time #ProcessAnalyticalTechnology (PAT) platform for #biomanufacturing. The mobile, modular system supports both process development and large-scale commercial #manufacturing. pharmamanufacturing.com/industry-news/… #Recipharm #biologics #CDMO #CDMOs
Learn how Bruker’s Fourier 80 NMR, coupled with @Syrris Asia System for flow chemistry, can support next-level flow photochemistry with a compact and highly responsive solution. Visit okt.to/psFKie #NMR #Pharma #ProcessAnalyticalTechnology #BenchtopNMR
Discover how synTQ is revolutionising manufacturing with real-time PAT solutions! Learn more in our latest brochure: optimal-tech.co.uk/wp-content/upl… #ProcessAnalyticalTechnology #SmartManufacturing
Discover how commercial & development knowledge can optimise near-infrared methods in PAT. Watch expert insights in this on-demand webinar: biopharmawebinars.com/webinars/lever… #ProcessAnalyticalTechnology #Biopharmaceuticals
Catch up on our on-demand webinar with Martin Gadsby, exploring how PAT is driving advances in bioprocessing & digital manufacturing. Watch now: biopharmawebinars.com/webinars/proce… #ProcessAnalyticalTechnology #Bioprocessing
biopharmawebinars.com
Process Analytical Technologies – Advances in Bioprocess From Integration to Transition to Digital...
Process Analytical Technology (PAT) instruments include analyzers capable of measuring physical and chemical process parameters and key attributes with the goal of optimizing process controls. PAT...
Explore how PAT is transforming bioprocessing and digital manufacturing with Martin Gadsby in this on-demand webinar. Watch now: biopharmawebinars.com/webinars/proce… #IndustrialAutomation #ProcessAnalyticalTechnology #Biomanufacturing
Maximize yield, quality, and sustainability with our Real-Time Reaction Analysis Guide! #SyntheticChemistry #ProcessAnalyticalTechnology #RealTimeAnalysis #Sustainability #Innovation #METTLERTOLEDO #AutoChem okt.to/QeCh0l
Cloud-based computing: driving next-generation drug development How can #processanalyticaltechnology be used when improving #pharmamanufacturing? ✏️Jonique Samuels, @OptimalLtd_Tech by #SciY Read here: bit.ly/3OJNbZs #AIandML #pharmatech #thecloud

📢 Unlocking Biopharma: WuXi's PAT Revolution! #wuxibiologics #ProcessAnalyticalTechnology #PAT #biopharma bioprocessupdates.com/automation-and…
bioprocessupdates.com
ᐈ Unlocking Biopharma: WuXi's PAT Revolution! - BioprocessUpdates
🌟 WuXi Biologics champions PAT in BioPharma, enhancing control and quality assurance for rapid therapy development! 📊🔬💡 BiotechInnovation
Curious about who we are and what we do at Optimal? Check out this video to see how we help businesses grow and improve processes! 🎥 youtube.com/watch?v=5tdVcu… #SmartManufacturing #ProcessAnalyticalTechnology
youtube.com
YouTube
An Introduction to the Optimal Group
Curious about who we are and what we do at Optimal? Check out this video to see how we help businesses grow and improve processes! 🎥 youtube.com/watch?v=5tdVcu… #SmartManufacturing #ProcessAnalyticalTechnology
youtube.com
YouTube
An Introduction to the Optimal Group
Discover how synTQ FM's fully flexible connectivity integrates seamlessly with any device for real-time optimisation and scalability. optimal-tech.co.uk/syntq/technica… #SmartManufacturing #ProcessAnalyticalTechnology #Automation
optimal-tech.co.uk
Technical Features of synTQ - Optimal
Technical Features of synTQ - Optimal
Looking for expert insights on how PAT can enhance pharma processes? Watch this on-demand webinar, featuring top speakers like Martin Gadsby, exploring the power of PAT! biopharmawebinars.com/webinars/next-… #ProcessAnalyticalTechnology #PharmaceuticalIndustry
biopharmawebinars.com
Next Generation Manufacturing at Biogen – PAT as an Enabler for Enhanced Process
Biogen is among the first biopharmaceutical companies to employ PAT in an active role in the manufacturing of biologicals. The implementation of in-process Raman for glucose control, biocapacitance...
Learn how synTQ can give companies a competitive edge and extend patent life by reducing R&D time and speeding up product release. Read more here: optimal-tech.co.uk/syntq/quality-… #ProcessAnalyticalTechnology #PharmaTech #SmartManufacturing
optimal-tech.co.uk
Quality and Commercial Gains - Optimal
Quality and Commercial Gains - Optimal
Our Innovations Team is driving the future of PAT with cutting-edge research and development Learn more about their groundbreaking work at Optimal here: optimal-tech.co.uk/optimal/the-op… #Innovation #ProcessAnalyticalTechnology #Automation
optimal-tech.co.uk
The Optimal Team - Optimal
The Optimal Team - Optimal
Unlock innovation & performance in pharma manufacturing with #ProcessAnalyticalTechnology (PAT) in @Emerson_News’ “DeltaV Spectral PAT for Life Sciences Podcast.” Hear from experts on leveraging PAT for success. Listen at hubs.ly/Q02Gz84l0 #GenerisPMOS #lifesciences
emersonautomationexperts.com
DeltaV Spectral PAT for Life Sciences Podcast
Jorge Costa & Bruce Greenwald discuss how DeltaV Spectral PAT easily connects with spectral analyzer multivariate data for better performance
Unlock innovation & performance in pharma manufacturing with #ProcessAnalyticalTechnology (PAT) in @Emerson_News’ “DeltaV Spectral PAT for Life Sciences Podcast.” Hear from experts on leveraging PAT for success. Listen at hubs.ly/Q02GyR9q0 #GenerisPMOS #lifesciences
emersonautomationexperts.com
DeltaV Spectral PAT for Life Sciences Podcast
Jorge Costa & Bruce Greenwald discuss how DeltaV Spectral PAT easily connects with spectral analyzer multivariate data for better performance
Discover how PAT strategies are driving continuous bioprocessing and rapid product release. Great read from @BioPharma_Asia! biopharma-asia.com/featured-artic… #ProcessAnalyticalTechnology #Bioprocessing
Cloud-driven PAT is transforming pharma with real-time monitoring and global collaboration. Discover more about this game-changing tech here: optimal-tech.co.uk/enhance-manufa… #ProcessAnalyticalTechnology #CloudComputing #PharmaTech
optimal-tech.co.uk
Enhance manufacturing by bringing PAT Knowledge to the Cloud - Optimal
Enhance manufacturing by bringing PAT Knowledge to the Cloud - Optimal
Video: Sensor receptacles reduce contamination, improve process yield in bioreactors insights.globalspec.com/article/14244/… #processanalyticaltechnology #pharmamanufacturing

Leveraging #processanalyticaltechnology (PAT) advancements helps companies derive value by combining data from process and analytical instruments with #advancedanalytics: hubs.ly/H0hryGg0 via Lisa Graham and @ISA_Interchange

Are you attending #APACT? Our #Fluorescence Product Manager, Dr @giogio_mar will be speaking today about how the A-TEEM technique can be used as a #ProcessAnalyticalTechnology in #biopharmaceutical production. Don't miss it! @cpact

#Indatech #GroupeChauvinArnoux #ProcessanalyticalTechnology #NIRSpectroscopy #HyperspectralImaging #ChemicalImaging #NIRCI #QualitybyDesign #QbD #Lyophilization #Freezedrying #PowderBlend

ADDR in Press: "Versatility on demand - The case for semi-solid micro-extrusion in pharmaceutics" By Jhinuk Rahman and Julian Quodbach @HHU_ZIM #3Dprinting #ProcessAnalyticalTechnology #microextrusion doi.org/10.1016/j.addr…

The #ProcessAnalyticalTechnology (PAT) framework, applied to chemical processes, enhances #productquality and consistency. Read our article with @ChemEngMag to learn about PAT benefits: ow.ly/JQ7T50I8oeg

LEARN MORE: ow.ly/phlE50DWI7z ------- #processanalyticaltechnology #bioprocess #monoclonalantibodies #cellculture #biotherapeuticmolecules ------- aspenalert.com -->> SUBSCRIBE TODAY!

The global #processanalyticaltechnology market size accounted for USD 2.94 billion in 2022 and is expected to touch around USD 8.21 billion by 2032, growing at a CAGR of 10.82% from 2023 to 2032. #precedenceresearch Read More: bit.ly/3MVtkXM

📌#datafusion #processanalyticaltechnology #chemometrics #processcontrol New Publication “Challenges and Opportunities of Implementing Data Fusion in Process Analytical Technology—A Review” By: Brigitta Nagy, et al. 👉 mdpi.com/1420-3049/27/1… #mdpimolecules #NewPublication

Cloud-based computing: driving next-generation drug development How can #processanalyticaltechnology be used when improving #pharmamanufacturing? ✏️Jonique Samuels, @OptimalLtd_Tech by #SciY Read here: bit.ly/3OJNbZs #AIandML #pharmatech #thecloud

[HypeReal Case Study] Enjoyed our dedicated webinar? Expand your knowledge of #ProcessAnalyticalTechnology and boost your productivity by studying HypeReal in action next week. Stay tuned! #NIRSpectroscopy #HyperspectralImaging #ChemicalImaging #NIRCI #Lyophilization #Indatech
![CA_Indatech's tweet image. [HypeReal Case Study] Enjoyed our dedicated webinar? Expand your knowledge of #ProcessAnalyticalTechnology and boost your productivity by studying HypeReal in action next week. Stay tuned! #NIRSpectroscopy #HyperspectralImaging #ChemicalImaging #NIRCI #Lyophilization #Indatech](https://pbs.twimg.com/media/Eck2N7tX0AQeDed.jpg)
[Note d'application HypeReal] Vous avez aimé notre webinar dédié? Complétez vos connaissances en #ProcessanalyticalTechnology et boostez votre productivité en découvrant l'HypeReal en situation dès la semaine prochaine, stay tuned ! #NIRSpectroscopy #HyperspectralImaging
![CA_Indatech's tweet image. [Note d'application HypeReal] Vous avez aimé notre webinar dédié? Complétez vos connaissances en #ProcessanalyticalTechnology et boostez votre productivité en découvrant l'HypeReal en situation dès la semaine prochaine, stay tuned ! #NIRSpectroscopy #HyperspectralImaging](https://pbs.twimg.com/media/Eck22q9WAAQ6IvJ.jpg)
Real-time quality assurance made easier by new partnership. Click here to read the article in full syntq.com/real-time-qual… #ProcessAnalyticalTechnology #PAT #synTQ #pharmaceutical #automatedqualityassurance

#synTQ V5 assists users develop the calibration models, process understanding and control models in the most time and cost-efficient way to form the pivotal role in your #ProcessAnalyticalTechnology (#PAT) project. optimal-ltd.co.uk #Software #IndustrialAutomation

📘Application of dielectric spectroscopy to monitor rAAV production @VoyagerTx 👉bit.ly/39HrIgs #ProcessAnalyticalTechnology #genetherapy #mdpiprocesses #AAV

Process Analytical Technology for High Shear Wet Granulation microbiozindia.com/process-analyt… @micromeritics #processanalyticaltechnology #phaarma

Join us 11/19 to hear experts from BASF Chemetall & #MetrohmUSA discuss advantages of #optimizedbathchemistry & #ProcessAnalyticalTechnology in the #surface treatment industry. Register👇🏽 event.on24.com/wcc/r/2785188/… #surfacefinishing #processanalytics #PAT #automationsolutions

Tomorrow! Leah Whiteker, Brad Herbert & Kraig Kmiotek talk #ProcessAnalyticalTechnology & how it has been implemented in different #industries. Register👉🏽event.on24.com/wcc/r/3525729/… #processanalytics #analyticalmeasurements #pat #automate #automation #processoptimization

Optimal as featured in the industry press. Thanks for the coverage. Find out more at optimal-ltd.co.uk #ProcessAnalyticalTechnology #PAT #synTQ #pharmaceutical




Hoeveel veiligheid heeft uw proces nodig? Onze nieuwe generatie 80 GHz radarsensoren bieden meer dan genoeg eh.digital/3W2ifph #EndressHauser #ProcessControl #ProcessAnalyticalTechnology

Something went wrong.
Something went wrong.
United States Trends
- 1. Inside the NBA 4,745 posts
- 2. Knicks 18.4K posts
- 3. East Wing 153K posts
- 4. #NewYorkForever 1,727 posts
- 5. Cavs 10.2K posts
- 6. #LetEmKnow 4,229 posts
- 7. Norman Powell N/A
- 8. Hamburger Helper 2,299 posts
- 9. Mobley 2,011 posts
- 10. Hukporti 1,147 posts
- 11. Mikal Bridges N/A
- 12. Jashanpreet Singh 4,332 posts
- 13. Brunson 3,986 posts
- 14. #drwfirstgoal N/A
- 15. Sion James N/A
- 16. Shaq 9,584 posts
- 17. Lonzo 1,906 posts
- 18. Charles Barkley 1,073 posts
- 19. Hornets 6,112 posts
- 20. Elander 3,869 posts